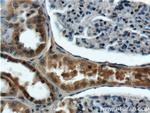
ANKRD6 Antibody in Immunohistochemistry (Paraffin) (IHC (P))

Search
Proteintech
ANKRD6 Polyclonal Antibody
{{$productOrderCtrl.translations['antibody.pdp.commerceCard.promotion.promotions']}}
{{$productOrderCtrl.translations['antibody.pdp.commerceCard.promotion.viewpromo']}}
{{$productOrderCtrl.translations['antibody.pdp.commerceCard.promotion.promocode']}}: {{promo.promoCode}} {{promo.promoTitle}} {{promo.promoDescription}}. {{$productOrderCtrl.translations['antibody.pdp.commerceCard.promotion.learnmore']}}
产品信息
24333-1-AP
种属反应
宿主/亚型
分类
类型
抗原
偶联物
形式
浓度
规格
纯化类型
保存液
内含物
保存条件
运输条件
产品详细信息
Immunogen sequence: MSQQDAVAA LSERLLVAAY KGQTENVVQL INKGARVAVT KHGRTPLHLA ANKGHLPVVQ ILLKAGCDLD VQDDGDQTAL HRATVVGNTE IIAALIHEGC ALDRQDKDGN TALHEASWHG FSQSAKLLVK AGANVLAKNK AGNTALHLAC QNSHSQSTRV LLLAGSRADL KNNAGDTCLH VAARYNHLSI IRLLLTAFCS VHEKNQAGDT ALHVAAALNH KKVAKILLEA GADTTIVNNA GQTPLETARY HNNPEVALLL T (1-260 aa encoded by BC042173)
靶标信息
Recruits CKI-epsilon to the beta-catenin degradation complex that consists of AXN1 or AXN2 and GSK3-beta and allows efficient phosphorylation of beta-catenin, thereby inhibiting beta-catenin/Tcf signals.
仅用于科研。不用于诊断过程。未经明确授权不得转售。
生物信息学
蛋白别名: Ankyrin repeat domain-containing protein 6; diego homolog; Diversin; epididymis secretory sperm binding protein; unnamed protein product
基因别名: ANKRD6; KIAA0957
UniProt ID: (Human) Q9Y2G4
Entrez Gene ID: (Human) 22881